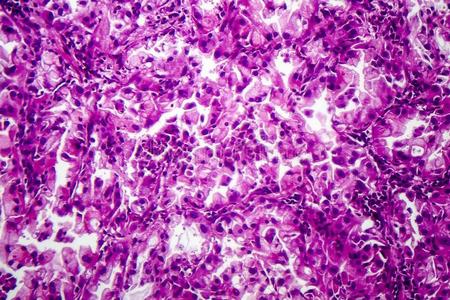
癌病理组织病理学说关于肺癌症照片

癌症组织

p>癌细胞扩散过程:癌症细胞在转移过程中会遇到很多困难,首先要经过
图片尺寸1200x792
透明细胞型肾细胞癌,癌组织呈鲜黄褐色或浅橙色,可呈实性或囊性,伴
图片尺寸583x443
7-295 成涎细胞瘤:肿瘤细胞核分裂易见图7-296 成涎细胞瘤:肿瘤组织坏
图片尺寸1268x834
术中困难重重,在成伟教授及杨晓军主任医师的组织下进行了多次术中
图片尺寸1080x1440
透明细胞型肾细胞癌,癌组织呈鲜黄褐色或浅橙色,可呈实性或囊性,伴
图片尺寸582x437
肿瘤剖开后可见黄色肿瘤组织伴出血坏死可以看到肿瘤的最外面有正常
图片尺寸2448x3264
女性常见恶性肿瘤疾病组织学分析
图片尺寸640x336
癌症癌细胞卡通图片_癌症癌细胞卡通图素材-癌症癌细胞卡通图片大全
图片尺寸329x185
免疫组织化学调宁蛋白染色显示肌上皮细胞包绕癌变肿瘤细胞
图片尺寸1632x654
图多形性腺瘤癌变详细图解唾液腺恶性肿瘤的临床病理
图片尺寸900x450
肿瘤学 肿瘤 放大倍数 妇科学 显微镜 癌症 子宫 组织病理学照片
图片尺寸450x300
多形性低度恶性腺癌以浸润性生长,细胞形态的单一性和组织结构的多样
图片尺寸1074x776
肾集合管癌,示肿瘤边界不清,可见不规则的小管状结构于肾组织中浸润性
图片尺寸661x496
在上个世纪八九十年代,人们发现癌症组织周围的血管系统可以被利用
图片尺寸1096x616
癌病理组织病理学说关于肺癌症照片
图片尺寸450x300
女性常见恶性肿瘤疾病组织学分析
图片尺寸640x336
透明细胞型肾细胞癌,呈囊性或巢片状结构肾组织中弥漫浸润的透明细胞
图片尺寸661x493
tpa全称组织多肽特异性抗原,是肿瘤标志物之一,同样没有特异性,如果
图片尺寸1200x753
导语:癌症是一种起源于上皮组织的恶性肿瘤,多数人听到这两个字总是
图片尺寸640x724
一例鼻小柱上唇肿胀诊断为纤维组织来源恶性肿瘤图
图片尺寸2336x4160